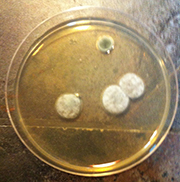
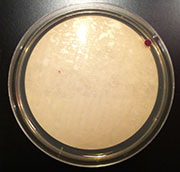

WashYourAir™ Total Home Solution
Continuous 24 Hour Indoor Environmental Protection

One unit can cover areas from 1,000 ft2 or up to 5,000 ft2
Available in three different stand-alone units or two different HVAC probes.
WashYourAir™ sanitizes both air and surfaces.
University tested to reduce surface bacteria MRSA, Airborne Microbial & Particulates.
WashYourAir™ breaks down odors (not captures them)
Odors in the home are broken down on a molecular level without chemicals.
Got Allergies? WashYourAir™ reduces pollen too!
Tested to reduce up to 99% of airborne particulates in just 3 days (W. Texas A&M).
Chemically Sensitive? WashYourAir™ breaks down VOCs
You will be amazed how WashYourAir™ can make VOC odors vanish.
Compact unit and Green Friendly
All three stand alone units stand only 15.5" tall and use only 15W of energy.
WashYourAir™ is safe and practically odorless.
Creates a very pleasant odorless environment in days without any heavy ion smell.
The CAP WashYourAir™ systems are noise free.
HVAC probes make no noise & the stand-alone units are quieter than HEPA filters.
WashYourAir™ is completely filterless.
No messy expensive filters to change that can cost up to $200/yr. for just one room!
Up to 99% airborne microbial reduction in just 3 days!

Without Air Fantastic
With Air Fantastic
(Same home after 2 weeks)
With Air Fantastic
(Same home after 6 months)
"The Mayo Clinic estimates that 37 million Americans have Chronic Sinusitis (sinusitis for more than 3 month) that is directly linked to airborne fungus and is an immune response. Antibiotics are not effective because they target bacteria, not fungi. Air Fantastic's WashYourAir ions can reduce up to 99% of airborne microbial."
Read entire Mayo Clinic's chronic sinusitis articleDon't filter your air... WashYourAir™!!

How It Works

Moisture & air enters unit from the bottom.

WashYourAir™ ions exits on top that continuously washes your air everywhere in your home.

Reduces up to 99% of airborne microbial (W. Texas A&M).

Breaks down odors and VOCs on the molecular level.

Also sanitized surface bacteria such as the hard-to-kill MRSA bacteria (W. Texas A&M).

Ions neutralized particulates (up to 99%) making them fall to the ground (W. Texas A&M).

After particulates are neutralized, they remain on the ground.



For more information
Call (877) 424-7326